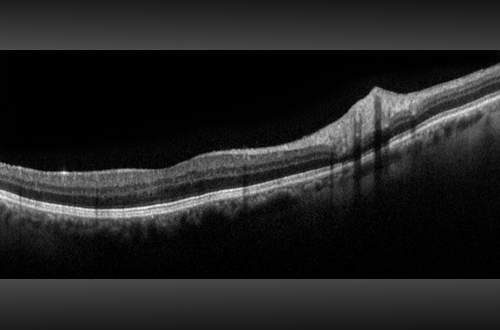

Description
Monaco est le seul appareil d’imagerie UWF avec SD-OCT intégré pour aider les professionnels de la vue à examiner et à améliorer l’économie des modalités d’imagerie et des options de visualisation d’images détaillées ci-dessous.
Monaco est une nouvelle approche intéressante pour améliorer votre examen clinique. Seul appareil d’imagerie de la rétine ultra-grand champ à posséder un SD-OCT intégré, Monaco produit une image optomap® à 200° en une seule prise en moins d’½ seconde ainsi que des vues transversales OCT à 40° des structures de la rétine. Monaco permet d’obtenir rapidement une image en plusieurs modalités avec balayages couleur, autofluorescence et OCT, pour les deux yeux, en seulement 90 secondes.
Monaco offre les avantages suivants :
- L’ultra-grand champ avec OCT intégré fait gagner du temps, de la place et minimise les mouvements du patient.
- L’OCT du pôle central apporte une imagerie multimodale complète.
- Les images optomap et les balayages OCT sont corrélés afin de faciliter l’examen des pathologies.
- Les images Couleur, AF et OCT sont présentées ensemble dans une même vue.
Spécifications techniques
| Modalités d’images | optomap couleur et optomap plus (laser rouge et vert) : Vue couleur composite Vue laser vert Vue laser rouge optomap af (laser vert) : autofluorescence Tomographie par cohérence optique (OCT) |
| Résolution | optomap plus: 14 μm optomap: 20 μm |
| Longueurs d’ondes | Laser rouge : 635 nm Laser vert : 532 nm (pour af ) |
| Temps d’exposition | Moins de 0,4 seconde |
| Imagerie tomographique | Type de signal : Diffusion optique du tissu Source du signal : Diode superluminescente 840 nm Puissance optique : Laser de classe 1 répondant à la norme IEC/EN60825-1:2014 Résolution axiale type : <10 microns (dans le tissu) Numérique à l’écran <6 microns Résolution transversale : 20 microns (dans le tissu) Scanners : Galvanométriques avec miroirs X-Y Profondeur du balayage : Jusqu’à 2,5 mm |
| Caractéristiques du balayage OCT | OCT en domaine spectral Fréquence de balayage A-scan jusqu’à 70 000 cycles/s Suivi actif de l’œil Positionnement automatique du balayage |
| Types de balayage OCT | Balayage linéaire Balayage de trame Balayage topographique de la rétine Balayage topographique de la tête du nerf optique (TNO) Balayage de la Couche des fibres nerveuses rétiniennes (CFNR) |
| Dimensions | Largeur : 550 mm Profondeur : 500 mm Hauteur : 650 mm |